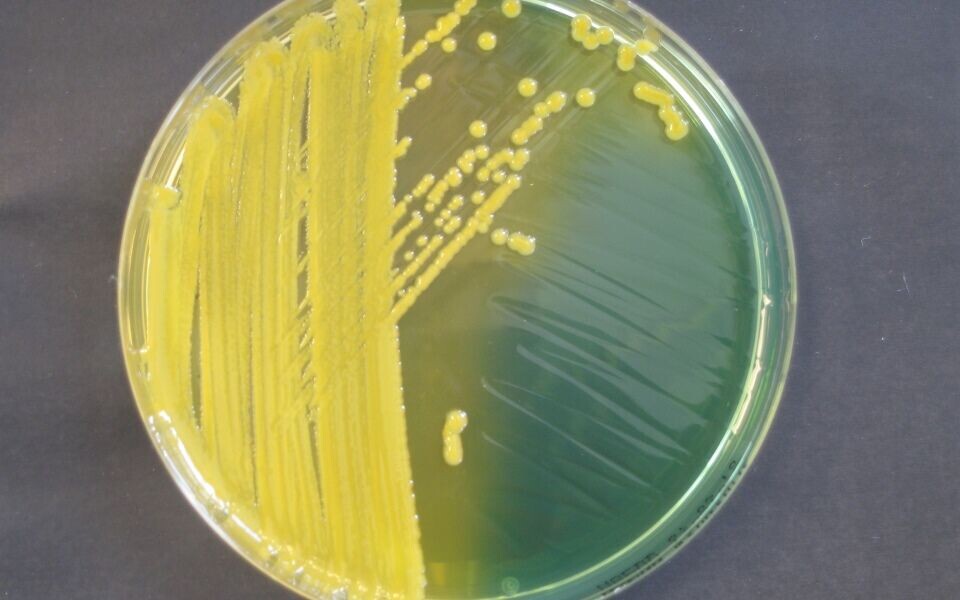

Aktuelt
Antibiotikaresistens: Foruroligende økning i fjor
Betydelig vekst i antall MRSA-bærerskap.Økende forekomst av karbapenemresistente stavbakterier.
I fjor ble det meldt om 1447 tilfeller av bærerskap med meticillinresistente Staphylococcus aureus (MRSA) i Norge. Det er mer enn dobbelt så mange tilfeller som i 2012. Antall infeksjoner i 2015 var 789, litt færre enn året før.
Tallene er hentet fra Folkehelseinstituttets årsrapport for 2015 om overvåkning av resistente bakterier.
Fra 2014 til 2015 har antall påviste bærerskap med MRSA økt med 40 prosent. Økningen kom i stor grad i de tre siste månedene av 2015. Samtidig kom det mange asylsøkere fra høyendemiske områder til Norge. Dette kan ha ført til økt testaktivitet, påpekes det i rapporten.
Tredobling i løpet av ett år
Karbapenemase-produserende Gram-negative stavbakterier (se faktaramme om ESBLKARBA) ble meldepliktige til MSIS i 2012. Resistensegenskapene hos slike bakterier gjør dem til en betydelig helsetrussel.
- Det er fortsatt få tilfeller i Norge, men antallet øker for hvert år. Utviklingen ligner på den man har sett i andre land, sier Ørjan Samuelsen, forsker ved Nasjonal kompetansetjeneste for påvisning av antibiotikaresistens.
I 2013 ble det påvist karbapenemase-produserende Enterobacteriaceae hos sju personer i Norge. I 2014 var det ti tilfeller, i fjor økte antallet til 30.
Det har særlig vært en økning i meldte tilfeller av Klebsiella pneumoniae med resistensmekanismene NDM og OXA-48. De fleste har blitt smittet i utlandet.
Utviklingen er foruroligende, står det i årsrapporten.
- Hva kan man gjøre for å motvirke denne trenden?
- I tillegg til en restriktiv bruk av antibiotika, er det viktig at sykehusene følger opp Folkehelseinstituttets anbefalinger for ESBL-screening av pasienter, sier Samuelsen.
VRE-utbrudd på retur
Flere norske sykehus har hatt utbrudd med Vankomycin-resistente enterokokker de senere årene. Antall meldte tilfeller har falt hvert år siden 2011. Da var det 291, i fjor var det 77.
- Men antall tilfeller har ikke falt tilbake til nivået før utbruddene startet, påpekes det i Folkehelseinstituttets rapport.
Kampanje mot resistens
Regjeringen har satt et mål om at antibiotikabruken i helsetjenesten skal ned med 30 prosent. I forslaget til revidert nasjonalbudsjett er det satt av fem millioner kroner til en nasjonal kampanje som skal informere befolkningen om sammenhengen mellom overforbruk av antibiotika og utvikling av resistens.
Folkehelseinstituttet har gjennomgått forskrivningspraksis i rapporten «Reseptregisteret 2011 – 2015». I 2012 ble det skrevet ut 450 resepter per 1000 innbyggere, i 2015 ble det skrevet ut 390.
Regjeringens mål er en reduksjon til 250 resepter per 1000 innbyggere i 2020.